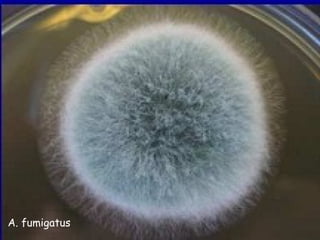
A. fumigatus
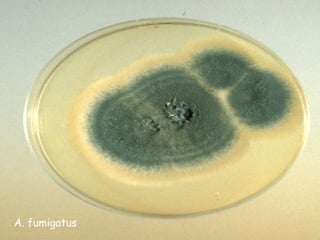
A. fumigatus
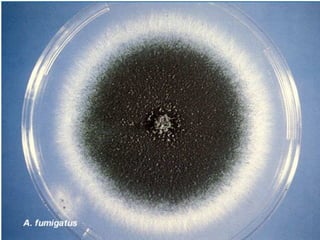
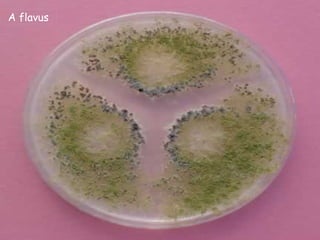
A flavus
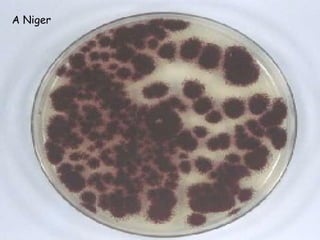
A Niger
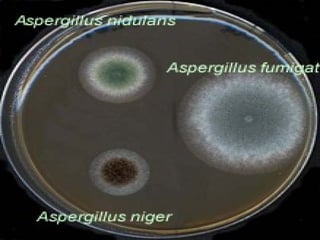
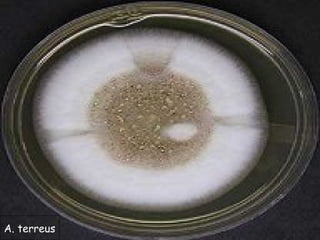
A. terreus
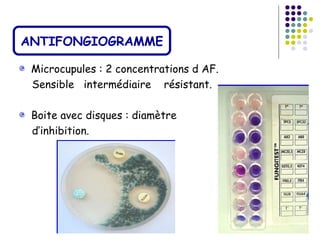
ANTIFONGIOGRAMME

 Microcupules : 2 concentrations d AF.
 Sensible intermédiaire résistant.

 Boite avec disques : diamètre
 d’inhibition.

Le document traite de l'aspergillose broncho-pulmonaire allergique (ABPA), une pneumopathie d'hypersensibilité causée par la colonisation des voies respiratoires par des moisissures du genre Aspergillus, particulièrement Aspergillus fumigatus. Il aborde la physiopathologie, le diagnostic positif incluant des tests cliniques et biologiques, ainsi que les méthodes de traitement, tout en répondant à l'importance de reconnaître cette maladie complexe, surtout chez les patients asthmatiques. En outre, le document souligne les défis diagnostiques et l'importance du traitement précoce pour éviter des formes graves de la maladie.